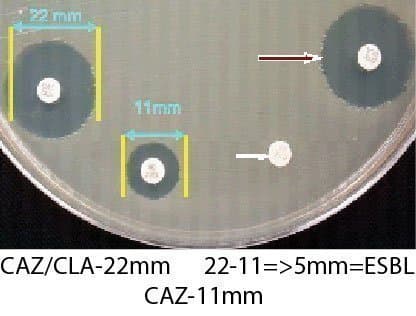
تشخيص فنوتيپی كلبسيلا پنومونيه مولد بتالاكتاماز وسيع الطيف(ESBL) با استفاده از روش كربی بائر

تشخيص فنوتيپی كلبسيلا پنومونيه مولد بتالاكتاماز وسيع الطيف(ESBL) با استفاده از روش كربی بائر
تشخيص فنوتيپی كلبسيلا پنومونيه مولد بتالاكتاماز وسيع الطيف(ESBL) با استفاده از روش كربی بائر
تشخيص فنوتيپی كلبسيلا پنومونيه مولد بتالاكتاماز وسيع الطيف(ESBL) با استفاده از روش كربي بائر، در اين روش بر اساس دستور العمل CLSI میتوان از ديسكهای سفتازيديم، سفتازيديم كلاونيك اسيد، سفوتاكسيم و سفوتاكسيم كلاونيك اسيد استفاده نمود. همانطور كه در تصوير فوق مشخص میباشد چنانچه كه قطر هاله عدم رشد ديسك همراه با كلاونيك اسيد ۵ ميلیمتر بيش از ديسك بدون كلاونيك اسيد آن باشد باكتری توليد كننده بتالاكتاماز وسيع الطيف میباشد. تشخيص و گزارش به موقع باكتریهای مقاوم به دارو جهت مداوای مناسب بيماران بسيار ارزشمند میباشد.